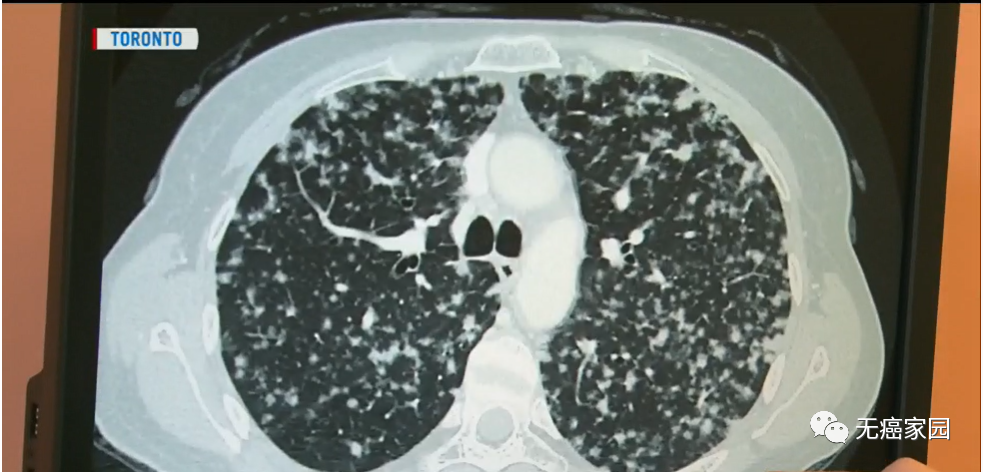
1-2.png

神奇的靶向药物 带来与肺癌共存7年 甚至16年的超级幸存者
近十年来,靶向药逐渐异军突起,发展壮大,迅速成为肿瘤治疗界的“新宠”,大有取代放化疗手段的趋势。尤其是晚期肺癌的5年生存率已经提高了四五倍!据无癌家园的专家表示,相信在未来10年,我们能够通过努力把转移性肺癌当作一个慢性病来处理。
小编最近查阅外文及国内位点看到许多关于晚期肺癌患者采用靶向治疗成为“超级响应者”的文章,下面会将他们的故事分享给各位癌友!
服用靶向药存活7年时间,她与肺癌达成“和解”
安妮·玛丽·塞拉托(Anne-Marie Cerato)是癌症专家分享的第一则病例,8年前,她注意到锁骨到有一个奇怪的肿块。经过一系列的检测,塞拉托如遭雷击般不敢相信自己居然得了肺癌。当时32岁的她一生中从未吸过一口烟,身体健康,没有任何疾病症状。
就在她接受一系列治疗的2年后,得到了更加毁灭性的消息:癌症已经扩散到她的另外一个肺部,无法进行手术治疗,她的病情也好似画上了休止符。
心灰意冷的她觉得命不久矣,辞去了教师的职务,开始环游世界。
她说道:“当时我觉得自己已经活了2年,也算是幸运的,这也许就是我的生活方式。我会尽最大的努力,当最后面临死亡的时候,会以朋友的身份向它打招呼。”

就在7年前,塞拉托克服重重困难,采用了靶向治疗的新型疗法。这种疗法是癌症医学的一种新趋势,超级幸存者的寿命比以往任何时候都要长。
在英国,像麦克米伦癌症支持组织这样的机构已经开始追踪这些“超级幸存者”,目前估计有17000人已经终生诊断多年,最重要的是,其中很多人都是健康的!
由于使用实验性药物来帮助控制癌症,许多癌症患者才得以幸存。虽然服用这些抗癌新药的患者没有被治愈,但是他们的癌症诊断从确定的死刑转变为可控制的慢性病,也算是极大的进步!
以塞拉托为例,她每天只服用两片劳拉替尼的靶向药进行治疗。之所以能够服用这种抗癌新药,全都源于她的肿瘤发生了ALK(间变性淋巴瘤激酶)基因突变,这种突变会发生在3%~5%的肺癌病例中。
英国麦克米伦癌症支持组织表示,随着“终末”诊断后出现的新生存趋势,需要定期扫描身体状况。
虽然生活方式很奇怪,需要每三周进行一次体检,甚至每隔一周扫描一次,但是7年后,她的生活状态很好,达到了与肺癌共存!她正在考虑重返工作岗位。她与其他被诊断出患有肺癌的患者交谈,并结识了她的伴侣帕特里克并与之结婚。

塞拉托说,由于身体健康,她一直很清楚自己有多幸运,并且在许多方面都争当先锋!
“我就像得到了一张彩票,使我获得了更多的时间。实际上,我并不在乎有多少时间,只要我能使现在的时间有意义即可。”

肺癌晚期,全身多处转移,带瘤生存16年
说到中国的靶向药治疗成功病例,有一位国宝级抗癌明星不得不提王瑛。
这是一位肺癌晚期广泛转移患者,2003年就被判“死刑”,但靠着正规治疗,尤其是靶向药物帮助下,存活了15年,而且越来越健康!相信科学,积极心态,再加上运气,她打破了传统结论,成了给无数人带来正能量的奇迹。

据无癌家园的专家介绍道:根据患者的基因突变,医生决定用特定药物的靶向治疗在肺癌中已经成为一种有效的治疗手段。截止到目前为止,已经有阳性意义基因突变的肺癌患者,已经达到非小细胞肺癌患者总数的70%,这意味着将有70%的非小细胞肺癌患者可以通过基因检测找到对应的靶向药物,从而延长生存周期,提高生存质量。
肺癌精准治疗,基因检测先行
小编给大家介绍完上述两位采用靶向药成功与肺癌共存的患者故事后,大家不禁会想,靶向药既然这么好,那是否能够人人都适用呢?其实并非如此!这是因为不同患者携带的突变基因存在差异,因此用药前应该通过基因检测。基因检测能够帮助肿瘤医生针对不同分子变异类型的患者,选择适合他们的治疗方案,从而实行靶向药物治疗。
肺癌可以分为小细胞肺癌和非小细胞肺癌,非小细胞癌又分为腺癌、鳞癌、腺鳞癌和大细胞癌,其中腺癌占主导地位,其次是鳞癌,而小细胞癌不到15%。
临床对于肺腺癌研究的比较多,发病机制研究比较清楚,导致肺腺癌突变的驱动基因突变70%~80%已被发现。在亚洲人群里面,最常见的是EGRF突变,其次是ALK、ROS1、KRAS等。肺腺癌的国内外治疗指南里面都强调了要做基因检测。此外,“无检测,不治疗”已经成为肺癌专科医师“必需”的诊疗行为,这无疑更强调了做基因检测的重要性!

对肺鳞癌来说,如果是活检小标本,不吸烟女性的肺鳞癌主张做基因检测,如果是吸烟的男性鳞癌,则指南不推荐做基因检测。
基因检测对免疫治疗也有一定价值。除了做PD-L1检测,还可以做基因检测来判断“肿瘤突变负荷(TMB)”。虽然现在还没有很强的证据,但对多线治疗(比如靶向治疗或者化疗)失败以后,考虑免疫治疗时可以检测。这时基因检测的目的不是为了找一个特定的靶点指导靶向治疗,而是去计算肿瘤的突变负荷。突变负荷高的患者可以推荐做免疫治疗。
目前非小细胞肺癌靶向药招募信息汇总
以下是目前无癌家园整理的非小细胞肺癌靶向药招募信息汇总,癌友们可以先收藏,或咨询无癌家园医学部酌情选择合适的药物治疗方案。

小编有话说
小编坚信,未来将会有越来越多的临床药物试验及免疫治疗技术及药物不断涌现,只要不放弃任何一点希望,攻克癌症指日可待!
参考文献
1.https://www.ctvnews.ca/health/new-drugs-changing-the-outlook-for-many-terminal-cancer-patients-1.3715693
2.https://www.healthcentral.com/condition/lung-cancer
3.https://ascopubs.org/doi/abs/10.1200/JCO.2020.38.15_suppl.9592